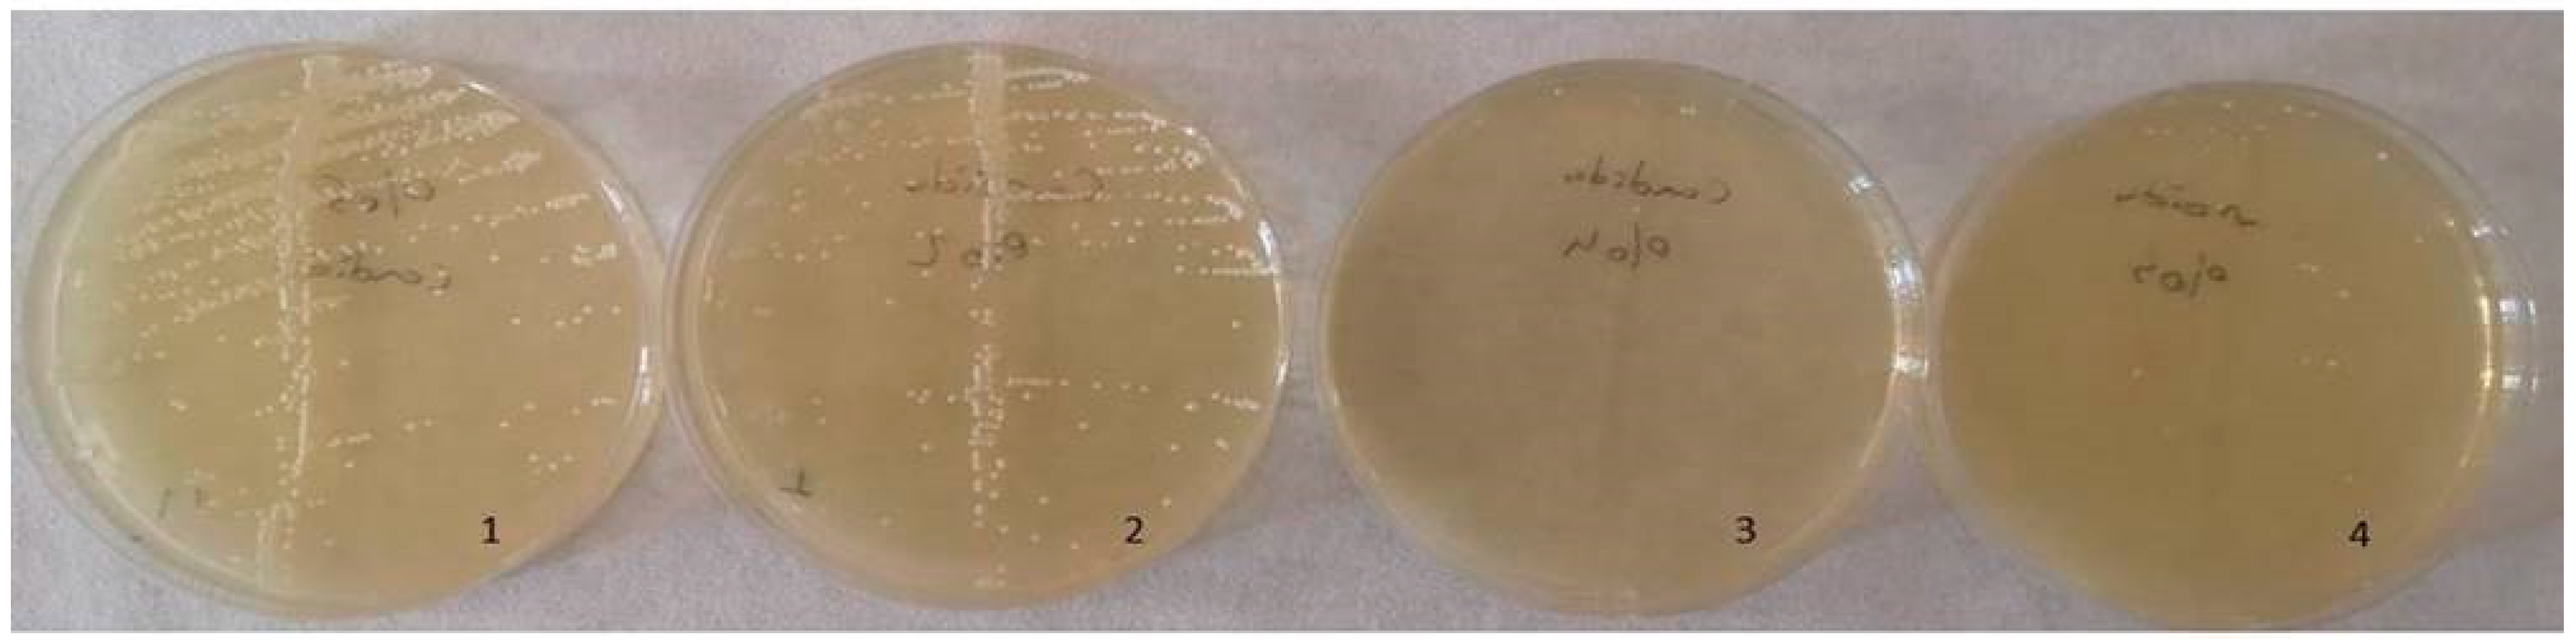
Inorganics 12 00258 g012
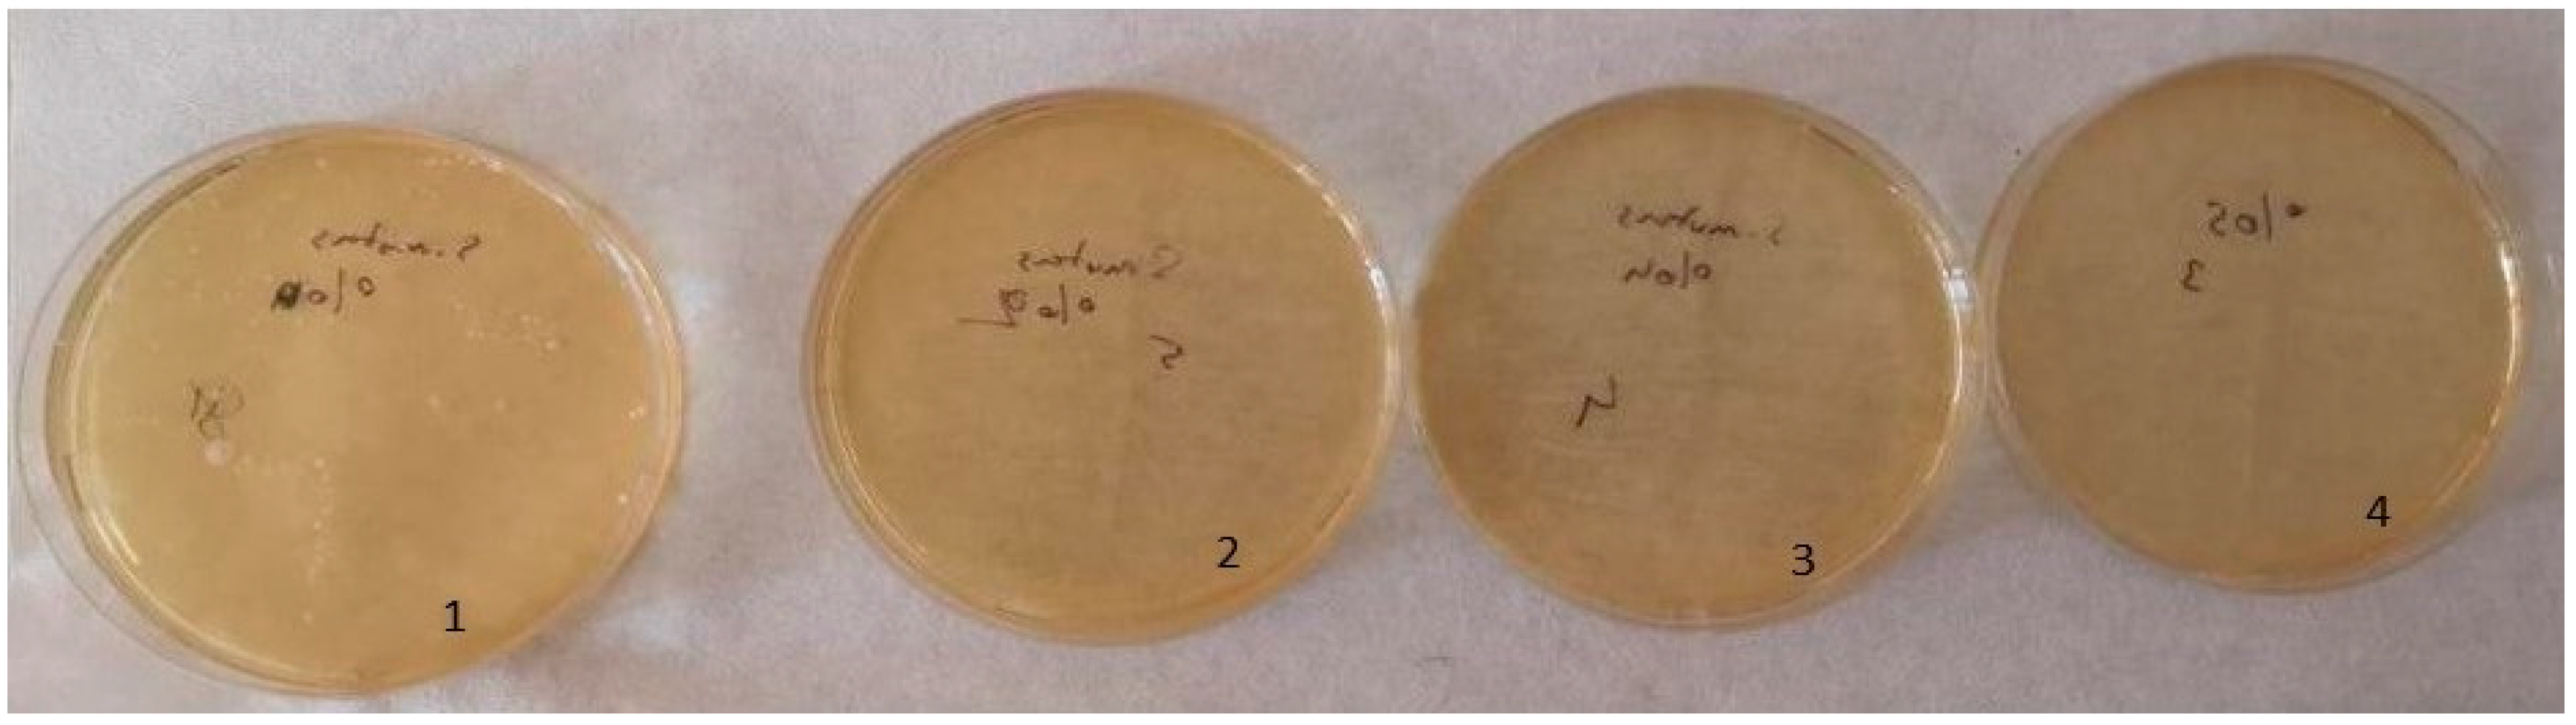
Inorganics 12 00258 g013

Antimicrobial, Optical, and Mechanical Properties of Saliva-Contaminated Silver–Zeolite Nanoparticle-Incorporated Dental Acrylic Resins
Abstract
:1. Introduction
2. Results
2.1. Surface Topography
2.2. Energy-Dispersive X-ray Analysis
2.3. Optical Test Results
2.4. Flexural Strength Test Results
2.5. SEM Analysis
2.6. Antimicrobial Test Results
3. Discussion
4. Materials and Methods
4.1. Antimicrobial Susceptibility Tests
4.1.1. Contamination of Discs with Microorganisms
4.1.2. Preparation of XTT and PMS Solutions
4.1.3. Bacterial Colonization
4.2. Optical Properties
4.3. Mechanical Properties
Scanning Electron Microscope (SEM)
4.4. Statistical Analysis
5. Conclusions
Author Contributions
Funding
Institutional Review Board Statement
Data Availability Statement
Acknowledgments
Conflicts of Interest
References
- Price, C. A history of dental polymers. Aust. Prosthodont. J. 1994, 8, 47–54. [Google Scholar] [PubMed]
- Lessa, F.C.R.; Enoki, C.; Ito, I.Y.; Faria, G.; Matsumoto, M.A.N.; Nelson-Filho, P. In-vivo evaluation of the bacterial contamination and disinfection of acrylic baseplates of removable orthodontic appliances. Am. J. Orthod. Dentofac. Orthop. 2007, 131, 705.e11–705.e17. [Google Scholar] [CrossRef] [PubMed]
- Rickman, L.J.; Padipatvuthikul, P.; Satterthwaite, J.D. Contemporary denture base resins: Part 1. Dent. Update 2012, 39, 25–28. [Google Scholar] [CrossRef] [PubMed]
- Malic, S.; Rai, S.; Redfern, J.; Pritchett, J.; Liauw, C.M.; Verran, J.; Tosheva, L. Zeolite-embedded silver extends antimicrobial activity of dental acrylics. Colloids Surf. B Biointerfaces 2019, 173, 52–57. [Google Scholar] [CrossRef] [PubMed]
- Sumi, Y.; Miura, H.; Michiwaki, Y.; Nagaosa, S.; Nagaya, M. Colonization of dental plaque by respiratory pathogens in dependent elderly. Arch. Gerontol. Geriatr. 2007, 44, 119–124. [Google Scholar] [CrossRef]
- Wady, A.; Machado, A.L.; Zucolotto, V.; Zamperini, C.; Berni, E.; Vergani, C.E. Evaluation of Candida albicans adhesion and biofilm formation on a denture base acrylic resin containing silver nanoparticles. J. Appl. Microbiol. 2012, 112, 1163–1172. [Google Scholar] [CrossRef]
- Valentini, F.; Luz, M.S.; Boscato, N.; Pereira-Cenci, T. Biofilm formation on denture liners in a randomised controlled in situ trial. J. Dent. 2013, 41, 420–427. [Google Scholar]
- Azeez, Z.A.; Fatah, N.A. The effect of incorporation of prepared Ag-Zn Zeolite on some properties of heat polymerized acrylic denture base materials. J. Baghdad Coll. Dent. 2015, 27, 63–69. [Google Scholar] [CrossRef]
- Saengmee-Anupharb, S.; Srikhirin, T.; Thaweboon, B.; Thaweboon, S.; Amornsakchai, T.; Dechkunakorn, S.; Suddhasthira, T. Antimicrobial effects of silver zeolite, silver zirconium phosphate silicate and silver zirconium phosphate against oral microorganisms. Asian Pac. J. Trop. Biomed. 2013, 3, 47–52. [Google Scholar] [CrossRef]
- Schneid, T.R. An in vitro analysis of a sustained release system for the treatment of denture stomatitis. Spec. Care Dent. 1992, 12, 245–250. [Google Scholar]
- Budtz-Jørgensen, E.; Mojon, P.; Banon-Clément, J.M.; Baehni, P. Oral candidiasis in long-term hospital care: Comparison of edentulous and dentate subjects. Oral Dis. 1996, 2, 285–290. [Google Scholar] [CrossRef] [PubMed]
- Nam, K.Y.; Lee, C.H.; Lee, C.J. Antifungal and physical characteristics of modified denture base acrylic incorporated with silver nanoparticles. Gerodontology 2012, 29, e413–e419. [Google Scholar]
- Buergers, R.; Rosentritt, M.; Handel, G. Bacterial adhesion of Streptococcus mutans to provisional fixed prosthodontic material. J. Prosthet. Dent. 2007, 98, 461–469. [Google Scholar] [PubMed]
- McCarthy, C.; Snyder, M.; Parker, R. The indigenous oral flora of man-I: The newborn to the 1-year-old infant. Arch. Oral Biol. 1965, 10, 61–70. [Google Scholar] [CrossRef] [PubMed]
- Paster, B.J.; Olsen, I.; Aas, J.A.; Dewhirst, F.E. The breadth of bacterial diversity in the human periodontal pocket and other oral sites. Periodontology 2006, 42, 80–87. [Google Scholar]
- Albandar, J.; Brunelle, J.; Kingman, A. Destructive periodontal disease in adults 30 years of age and older in the United States. J. Periodontol. 1999, 70, 13–29. [Google Scholar]
- Uçar, Y.; Bakar, O.; Ekinci, M.; Kayar, B. Poliamid ile farklı polimetilmetakrilat protez kaide materyallerinin mikroorganizma tutulumunun karşılaştırılması. SDÜ Tıp Fak. Derg. 2013, 20, 8–13. [Google Scholar]
- Li, L.; Redding, S.; Dongari-Bagtzoglou, A. Candida glabrata, an emerging oral opportunistic pathogen. J. Dent. Res. 2007, 86, 204–215. [Google Scholar]
- Abe, Y.; Ishii, M.; Takeuchi, M.; Ueshige, M.; Tanaka, S.; Akagawa, Y. Effect of saliva on an antimicrobial tissue conditioner containing silver–zeolite. J. Oral Rehabil. 2004, 31, 568–573. [Google Scholar] [CrossRef]
- Alla, R.; Raghavendra, K.; Vyas, R.; Konakanchi, A. Conventional and contemporary polymers for the fabrication of denture prosthesis: Part I–overview, composition and properties. Int. J. Appl. Dent. Sci. 2015, 1, 82–89. [Google Scholar]
- Galav, A.; Deogade, S.C.; Mantri, S.; Sumathi, K.; Galav, S. Effect of water storage on the flexural strength of heat-cured denture base resin reinforced with stick(s) glass fibers. Contemp. Clin. Dent. 2017, 8, 264–271. [Google Scholar] [PubMed]
- Khosravani, M.R. Mechanical behavior of restorative dental composites under various loading conditions. J. Mech. Behav. Biomed. Mater. 2019, 93, 151–157. [Google Scholar] [CrossRef] [PubMed]
- Gad, M.M.; Fouda, S.M.; Al-Harbi, F.A.; Näpänkangas, R.; Raustia, A.N. PMMA denture base material enhancement: A review of fiber, filler, and nanofiller addition. Int. J. Nanomed. 2017, 12, 3801–3812. [Google Scholar] [CrossRef] [PubMed]
- Oka, H.; Tomioka, T.; Tomita, K.; Nishino, A.; Ueda, S. Inactivation of enveloped viruses by a silver-thiosulfate complex. Met. Drugs 1994, 1, 511. [Google Scholar] [CrossRef] [PubMed]
- Tokumaru, T.; Shimizu, Y.; Fox, J.R.C. Antiviral activities of silver sulfadiazine in ocular infection. Res. Commun. Chem. Pathol. Pharmacol. 1974, 8, 151–158. [Google Scholar]
- Alt, V.; Bechert, T.; Steinrucke, P.; Wagener, M.; Seidel, P.; Dingeldein, E.; Domann, E.; Schnettler, R. An in vitro assessment of the antibacterial properties and cytotoxicity of the nanoparticles silver bone cement. Biomaterials 2004, 25, 4383–4391. [Google Scholar] [CrossRef]
- Samuel, U.; Guggenbichler, J.P. Prevention of catheter- related infections: The potential of a new nanosilver impregnated catheter. Int. J. Antimicrob. Agents 2004, 23, 75–78. [Google Scholar] [CrossRef]
- Wright, J.B.; Lam, K.; Hansen, D.; Burrell, R. Efficacy of topical silver against fungal burn wound pathogens. Am. J. Infect. Control 1999, 27, 344–350. [Google Scholar] [CrossRef]
- Ranjitha, V.; Reddy, K.M.; Shastry, Y.M. Effects of silver nanoparticles addition on flexural strength and surface roughness of heat polymerized acrylic resin-An in-vitro study. J. Adv. Med. Dent. Sci. Res. 2022, 10, 87–91. [Google Scholar]
- Nikawa, H.; Yamamoto, T.; Hamada, T.; Rahardjo, M.; Murata, H.; Nakanoda, S. Antifungal effect of zeolite-incorporated tissue conditioner against Candida albicans growth and/or acid production. J. Oral Rehabil. 1997, 24, 350–357. [Google Scholar]
- Feng, Q.L.; Wu, J.; Chen, G.Q.; Cui, F.; Kim, T.; Kim, J.A. mechanistic study of the antibacterial effect of silver ions on Escherichia coli and Staphylococcus aureus. Biomed. Mater. Res. 2000, 52, 662–668. [Google Scholar] [CrossRef]
- Cheun, K. Antibacterial activity of A-type zeolite supporting silver ions in deionized distilled water. J. Antibact. Antifung. Agent. 1996, 24, 269–274. [Google Scholar]
- Inoue, Y.; Hoshino, M.; Takahashi, H.; Noguchi, T.; Murata, T.; Kanzaki, Y.; Hamashima, H.; Sasatsu, M. Bactericidal activity of Ag–zeolite mediated by reactive oxygen species under aerated conditions. J. Inorgan. Biochem. 2002, 92, 37–42. [Google Scholar]
- Asar, N.V.; Albayrak, H.; Korkmaz, T.; Turkyilmaz, I. Influence of various metal oxides on mechanical and physical properties of heat-cured polymethyl methacrylate denture base resins. J. Adv. Prosthodont. 2013, 5, 241–247. [Google Scholar] [CrossRef]
- Abdulridha, W.M.; Almusawi, R.M.; Al-Jubouri, O.M.; Wally, Z.J.; Zidan, S.; Haider, J.; Al-Quraine, N.T. Studying the effect of adding Titanium Dioxide (TiO2) nanoparticles on the compressive strength of chemical and heat-activated acrylic denture base resins. Adv. Mater. Process. Technol. 2020, 8, 1058–1070. [Google Scholar] [CrossRef]
- Casemiro, L.A.; Martins, C.H.G.; Pires-de-Souza, F.C.P.; Panzeri, H. Antimicrobial and mechanical properties of acrylic resins with incorporated silver-zinc zeolite part I. Gerodontology 2008, 25, 187–194. [Google Scholar] [CrossRef]
- de Souza Leão, R.; de Moraes, S.L.D.; de Luna Gomes, J.M.; Lemos, C.A.A.; da Silva Casado, B.G.; do Egito Vasconcelos, B.C.; Pellizzer, E.P. Influence of addition of zirconia on PMMA: A systematic review. Mater. Sci. Eng. C 2020, 106, 110292. [Google Scholar]
- Darwish, M.; Nassani, M.Z. Evaluation of the effect of denture adhesives on surface roughness of two chemically different denture base resins. Eur. J. Dent. 2016, 10, 321–326. [Google Scholar] [CrossRef]
- Keng, S.B.; Lim, M. Denture plaque distribution and the effectiveness of a perborate-containing denture cleanser. Quintessen Intern. 1996, 27, 341–345. [Google Scholar]
- Sen, B.H.; Chugal, N.M.; Liu, H.; Fleischmann, J.A. new method for studying the adhesion of Candida albicans to dentin in the presence or absence of smear layer. Oral Surg. Oral Med. Oral Pathol. Oral Radiol. Endodontology 2003, 96, 201–206. [Google Scholar]
- Koban, I.; Matthes, R.; Hübner, N.O.; Welk, A.; Sietmann, R.; Lademann, J.; Kramer, A.; Kocher, T. XTT assay of ex vivo saliva biofilms to test antimicrobial influences. GMS Krankenhaushygiene Interdiszip. 2012, 7. [Google Scholar] [CrossRef]
- Ozel, G.S.; Guneser, M.B.; Inan, O.; Eldeniz, A.U. Evaluation of C. albicans and S. mutans adherence on different provisional crown materials. J. Adv. Prosthodont. 2017, 9, 335–340. [Google Scholar] [CrossRef] [PubMed]
- Li, Z.; Sun, J.; Lan, J.; Qi, Q. Effect of a denture base acrylic resin containing silver nanoparticles on Candida albicans adhesion and biofilm formation. Gerodontology 2016, 3, 209–216. [Google Scholar] [CrossRef] [PubMed]
- Nakanoda, S.; Nikawa, H.; Hamada, T.; Yamamoto, T.; Nakamoto, K. The material and antifungal properties of antibiotic zeolite incorporated acrylic resin. J. Jpn. Prosthodont. Soc. 1995, 39, 919–926. [Google Scholar] [CrossRef]
- Kuroki, K.; Hayashi, T.; Sato, K.; Asai, T.; Okano, M.; Kominami, Y.; Takahashi, Y.; Kawai, T. Effect of self-cured acrylic resin added with an inorganic antibacterial agent on Streptococcus mutans. Dent. Mater. J. 2010, 29, 277–285. [Google Scholar] [CrossRef]
- Dao, P.H.; Nguyen, T.D.; Nguyen, T.C.; Nguyen, A.H.; Mac, V.P.; Tran, H.T.; Phung, T.L.; Vu, Q.T.; Vu, D.H.; Ngo, T.C.Q.; et al. Assessment of some characteristics, properties of a novel waterborne acrylic coating incorporated TiO2 nanoparticles modified with silane coupling agent and Ag/Zn zeolite. Prog. Org. Coat. 2022, 163, 106641. [Google Scholar] [CrossRef]
- Aljafery, A.M.; Al-Jubouri, O.M.; Wally, Z.J.; Almusawi, R.M.; Abdulrudha, N.H.; Haider, J. The Effects of Incorporating Ag-Zn Zeolite on the Surface Roughness and Hardness of Heat and Cold Cure Acrylic Resins. J. Compos. Sci. 2022, 6, 85. [Google Scholar] [CrossRef]
- Karcı, M.; Demir, N.; Yazman, Ş. Farklı Nanopartiküllerle Güçlendirilen Mikrodalga Enerjisi İle Polimerize Olan Akrilik Rezinin Mekanik Ve Fiziksel Özelliklerinin Değerlendirilmesi. Atatürk Üniversitesi Diş Hekim. Fakültesi Derg. 2017, 30, 101–106. [Google Scholar]
- Karamustafa, F. Akrilik Rezin Materyallerine Farklı Oranlarda çay Ağacı Yağı Eklenmesinin Candida Albicans İnhibisyonuna ve Materyallerin Yüzey Pürüzlülüğüne Etkisi. Ph.D. Thesis, Karadeniz Teknik Üniversitesi, Trabzon, Türkiye, 2021. [Google Scholar]
- Khatoon, N.; Sharma, Y.; Sardar, M.; Manzoor, N. Mode of action and anti-Candida activity of Artemisia annuamediated-synthesized silver nanoparticles. J. Mycol. Med. 2019, 29, 201–209. [Google Scholar] [CrossRef]
- Haque, F.; Alfatah, M.; Ganesan, K.; Bhattacharyya, M.S. Inhibitory effect of sophorolipid on Candida albicans biofilm formation and hyphal growth. Sci. Rep. 2016, 6, 235–275. [Google Scholar] [CrossRef]
- Jimenez, L.; Ignar, R.; Smalls, S.; Grech, P.; Hamilton, J.; Bosko, Y.; English, D. Molecular detection of bacterial indicators in cosmetic/pharmaceuticals and raw materials. J. Ind. Microbiol. Biotechnol. 1999, 22, 93–95. [Google Scholar] [CrossRef]
- Huang, J.; Hitchins, A.D.; Tran, T.T.; McCarron, J.E. Bacteriological Analytical Manual Chapter 23: Methods for Cosmetics. July 2024 Edition. pp. 1–15. Available online: https://www.fda.gov/media/177960/download (accessed on 22 September 2024).
- Nam, K.Y. Characterization and antifungal activity of the modified PMMA denture base acrylic: Nanocomposites impregnated with gold, platinum, and silver nanoparticles. Nanobiomater. Dent. 2016, 11, 309–336. [Google Scholar]
- Kasraei, S.; Azarsina, M. Addition of silver nanoparticles reduces the wettability of methacrylate and silorane-based composites. Br. Dent. J. 2012, 26, 505–510. [Google Scholar] [CrossRef] [PubMed]
- Petering, H.G. Pharmacology and toxicology of heavy metals: Silver. Pharmacol. Ther. 1976, 1, 127–130. [Google Scholar] [CrossRef]
- Ramage, G.; Vande Walle, K.; Wickes, B.L.; López-Ribot, J.L. Standardized method for in vitro antifungal susceptibility testing of Candida albicans biofilms. Antimicrob. Agents Chemother. 2001, 45, 2475–2479. [Google Scholar] [CrossRef]
- Mutneja, P.; Raghavendraswamy, K.N.; Gujjari, A.K. Flexural strength of heat cure acrylic resin after incorporation of different percentage of Silver zinc zeolite- an in-vitro study. IJCI 2013, 4, 25–31. [Google Scholar]
- Takahashi, T.; Gonda, T.; Maeda, Y. The influence of reinforcement on strain in maxillary complete dentures: A preliminary report. Int. J. Prosthodont. 2011, 24, 273–276. [Google Scholar]
- Kamonkhantikul, K.; Arksornnukit, M.; Takahashi, H. Antifungal, optical, and mechanical properties of polymethylmethacrylate material incorporated with silanized zinc oxide nanoparticles. Int. J. Nanomed. 2017, 12, 2353–2360. [Google Scholar] [CrossRef]
- Sodagar, A.; Khalil, S.; Kassaee, M.Z.; Shahroudi, A.S.; Pourakbari, B.; Bahador, A. Antimicrobial properties of poly (methyl methacrylate) acrylic resins incorporated with silicon dioxide and titanium dioxide nanoparticles on cariogenic bacteria. J. Orthodont. Sci. 2016, 5, 7. [Google Scholar]
- Ferreira, L.; Guedes, J.F.; Almeida-Aguiar, C.; Fonseca, A.M.; Neves, I.C. Microbial growth inhibition caused by Zn/Ag-Y zeolite materials with different amounts of silver. Colloids Surf. B Biointerfaces 2016, 142, 141–147. [Google Scholar] [CrossRef]
- Craig, R.G.P.J.; Wataha, J.C. Dental Polymers. In Dent Mater, Properties and Manipulation, 11th ed.; C. V. Mosby Company: St. Louis, MO, USA, 2001. [Google Scholar]
- Standardization of Dentistry: Denture Base Polymer; International Organization for Standardization: Geneva, Switzerland, 1999.
- Addy, M.; Handley, R. The effects of the incorporation of chlorhexidine acetate on some physical properties of polymerized and plasticized acrylics. J. Oral Rehabil. 1981, 8, 155–163. [Google Scholar] [CrossRef] [PubMed]
- Murat, S. Gümüş zeolit ilave edilen akrilik rezinlerin eğilme dayanimlarinin in-vitro değerlendirilmesi. Atatürk Ünv. Diş Hek. Fak. Derg. 2018, 4, 539–544. [Google Scholar]
- Yadav, N.S.; Saraf, S.; Mishra, S.K.; Hazari, P. Effects of fluconazole, chlorhexidine gluconate, and silver-zinc zeolite on flexural strength of heat-cured polymethyl methacrylate resin. J. Nat. Sci. Biol. Med. 2015, 6, 340. [Google Scholar]
- Shibata, T.; Hamada, N.; Kimoto, K.; Sawada, T.; Kumada, H.; Umemoto, T.; Toyoda, M. Antifungal effect of acrylic resin containing apatite-coated TiO2 photocatalyst. Dent. Mater. J. 2007, 26, 437–444. [Google Scholar] [CrossRef] [PubMed]
- Shan, Y.; Bai, Y.; Yang, S.; Zhou, Q.; Wang, G.; Zhu, B.; Zhou, Y.; Fang, W.; Wen, N.; He, R.; et al. 3D-printed strontium-incorporated β-TCP bioceramic triply periodic minimal surface scaffolds with simultaneous high porosity, enhanced strength, and excellent bioactivity. J. Adv. Ceram. 2023, 12, 1671–1684. [Google Scholar] [CrossRef]
- Kassaee, M.; Akhavan, A.; Sheikh, N.; Sodagar, A. Antibacterial effects of a new dental acrylic resin containing silver nanoparticles. J. Appl. Polym. Sci. 2008, 110, 1699–1703. [Google Scholar] [CrossRef]
- Wakasa, K. A fundamental study on dental application of silver zeolite. J. Hiroshima Univ. Dent. Soc. 1997, 29, 87–98. [Google Scholar]
- Ren, J.; Lin, H.; Huang, Q.; Liang, Q.; Zheng, G. Color difference threshold determination for acrylic denture base resins. Bio-Med. Mater. Eng. 2015, 26, S35–S43. [Google Scholar] [CrossRef]
- Paravina, R.D.; Ghinea, R.; Herrera, L.J.; Bona, A.D.; Igiel, C.; Linninger, M.; Sakai, M.; Takahashi, H.; Tashkandi, E.; Perez, M.d.M. Color difference thresholds in dentistry. J. Esthet. Restor. Dent. 2015, 27, S1–S9. [Google Scholar] [CrossRef]
- Ren, J.; Lin, H.; Huang, Q.; Zheng, G. Determining color difference thresholds in denture base acrylic resin. J. Prosthet. Dent. 2015, 114, 702–708. [Google Scholar] [CrossRef]
- Alp, G.; Johnston, W.M.; Yilmaz, B. Optical properties and surface roughness of prepolymerized poly (methyl methacrylate) denture base materials. J. Prosthet. Dent. 2019, 121, 347–352. [Google Scholar] [CrossRef] [PubMed]
- O’brien, W.J. Dental Materials and Their Selection; Quintessence: Carol Stream, IL, USA, 2002. [Google Scholar]
- Yilmaz, B.; Karaagaclioglu, L. In vitro evaluation of color replication of metal ceramic specimens using visual and instrumental color determinations. J. Prosthet. Dent. 2011, 105, 21–27. [Google Scholar] [CrossRef] [PubMed]

| Group | n | Min | Max | Mean | SDPMA | p |
|---|---|---|---|---|---|---|
| 0–2% | 10 | 2.48 | 3.48 | 2.87 | 0.27 a | <0.001 |
| 0–4% | 10 | 4.91 | 5.88 | 5.41 | 0.36 b | |
| 0–5% | 10 | 5.72 | 6.63 | 6.17 | 0.27 c | |
| 2–4% | 10 | 2.78 | 4.06 | 3.23 | 0.44 d | |
| 2–5% | 10 | 3.46 | 5.09 | 4.22 | 0.44 e | |
| 4–5% | 10 | 1.25 | 1.84 | 1.52 | 0.21 f |
| Groups n | Min | Max | Mean | SD | p |
|---|---|---|---|---|---|
| 0% Ag/Z 10 | 76.80 | 84.00 | 80.28 a | 2.49 | <0.001 |
| 2% Ag/Z 10 | 56.40 | 75.60 | 65.40 b | 5.46 | |
| 4% Ag/Z 10 | 48.00 | 79.20 | 65.40 b | 10.99 | |
| 5% Ag/Z 10 | 37.20 | 69.60 | 60.36 c | 10.25 |
| Group | Mean ± SD | Min–Max | p | |
|---|---|---|---|---|
| S. mutans (490 nm) | 0% Group | 0.272 ± 0.079 a | 0.128–0.361 | <0.001 |
| 2% Group | 0.120 ± 0.014 bc | 0.103–0.140 | ||
| 4% Group | 0.128 ± 0.015 b | 0.117–0.158 | ||
| 5% Group | 0.097 ± 0.018 c | 0.080–0.131 | ||
| C. albicans (490 nm) | %0 Group | 0.154 ± 0.010 b | 0.138–0.170 | <0.001 |
| 2% Group | 0.119 ± 0.017 a | 0.100–0.143 | ||
| 4% Group | 0.155 ± 0.023 b | 0.132–0.199 | ||
| 5% Group | 0.145 ± 0.012 b | 0.128–0.159 |
| C. albicans | S. mutans | |
|---|---|---|
| 0% | 100,000 (100,000–100,000) c | 100,000 (50,000–100,000) b |
| 2% | 80,000 (50,000–90,000) bc | 0 (0–0) a |
| 4% | 10,000 (5000–50,000) ab | 0 (0–0) a |
| 5% | 5000 (5000–20,000) a | 0 (0–0) a |
| p | <0.001 | <0.001 |
Disclaimer/Publisher’s Note: The statements, opinions and data contained in all publications are solely those of the individual author(s) and contributor(s) and not of MDPI and/or the editor(s). MDPI and/or the editor(s) disclaim responsibility for any injury to people or property resulting from any ideas, methods, instructions or products referred to in the content. |
© 2024 by the authors. Licensee MDPI, Basel, Switzerland. This article is an open access article distributed under the terms and conditions of the Creative Commons Attribution (CC BY) license (https://creativecommons.org/licenses/by/4.0/).
Share and Cite
Yaman, Ç.K.; Demir, N.; Arslan, U.; Çiftçi, N. Antimicrobial, Optical, and Mechanical Properties of Saliva-Contaminated Silver–Zeolite Nanoparticle-Incorporated Dental Acrylic Resins. Inorganics 2024, 12, 258. https://doi.org/10.3390/inorganics12100258
Yaman ÇK, Demir N, Arslan U, Çiftçi N. Antimicrobial, Optical, and Mechanical Properties of Saliva-Contaminated Silver–Zeolite Nanoparticle-Incorporated Dental Acrylic Resins. Inorganics. 2024; 12(10):258. https://doi.org/10.3390/inorganics12100258
Chicago/Turabian StyleYaman, Çisel Kısa, Necla Demir, Uğur Arslan, and Nurullah Çiftçi. 2024. "Antimicrobial, Optical, and Mechanical Properties of Saliva-Contaminated Silver–Zeolite Nanoparticle-Incorporated Dental Acrylic Resins" Inorganics 12, no. 10: 258. https://doi.org/10.3390/inorganics12100258
APA StyleYaman, Ç. K., Demir, N., Arslan, U., & Çiftçi, N. (2024). Antimicrobial, Optical, and Mechanical Properties of Saliva-Contaminated Silver–Zeolite Nanoparticle-Incorporated Dental Acrylic Resins. Inorganics, 12(10), 258. https://doi.org/10.3390/inorganics12100258






